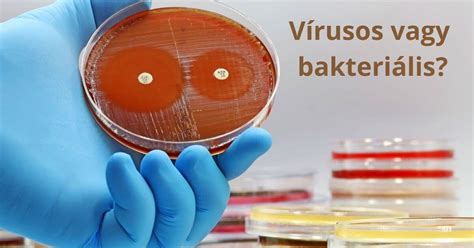
Bakteriális fertőzések illusztrációja

A kutya az ember legjobb barátja, ám néha nézeteltéréseiket harapással jelzik felénk. Ennek a cikknek nem célja megállapítani, mi vezetett a harapáshoz, ahogyan az sem, hogyan lehetett volna megelőzni azt. Általánosságban annyit tudok mondani, hogy kisbabát kutyával, tapasztalatom szerint, amit a gyermek-traumatológiai ambulancián szereztem, cirka 15 év alatt, nem szabad egyedül hagyni!
Statisztikák szerint minden ötödik kutyaharapás olyan sérülést okoz, amely orvosi ellátást igényel, és a gyerekek többnyire gyakrabban sérülnek meg a kutyusok hevesebb reakciói által, mint a felnőttek. A kutyaharapás nagyon veszélyes lehet, ha a blöki nem rendelkezik veszettség elleni védőoltással, valamint gyakori, hogy a harapott seb a baktériumok következtében elfertőződik.
A kutyák, mivel fogazatuk szerint húsevő állatok, rendkívül változatos sebeket tudnak okozni. Beszélhetünk kutyaharapás esetén: szúrt, tépett, zúzott sebekről, de törhetnek csontok is. Viszont kutyák okozta sebzések valójában nem emiatt érdekesek. A kutyák által okozott seb abban különbözik, például egy vágott sebtől, hogy a kutya szájában sok olyan baktérium és vírus található, melyek később gondot okozhatnak.
A Kutyaharapás Létrehozta Sérülések Jellege
A kutyaharapás nagyon veszélyes lehet, hiszen erős állkapcsának köszönhetően már egy kisebb méretű eb is komoly sebeket tud ejteni, amelyek ráadásul könnyen elfertőződhetnek. A kutyák által okozott seb abban különbözik, például egy vágott sebtől, hogy a kutya szájában sok olyan baktérium és vírus található, melyek később gondot okozhatnak. A kutyák által okozott sebzések lehetnek szúrt, tépett, zúzott sebek, és csonttörés is előfordulhat.

Veszélyes Betegségek Kutyaharapás Esetén
A kutyaharapás két fő veszélyt rejt magában: a veszettséget és a sebbe jutó kórokozó baktériumok okozta fertőzéseket. Dr. Nyiri Péter ortopéd sebész, traumatológus szerint a kutyaharapás a mi szemszögünkből két lehetséges veszélyt rejt magában: az egyik a veszettség, a másik a harapáson keresztül a szövetekbe jutó kórokozó baktériumok, leggyakrabban gennykeltők.
Veszettség
A veszettséget egy vírus, a Rabies lyssa okozza. Ez a vírus ott élhet a kutyák nyálában, agy- és gerincvelő-gyulladást okoz, és oltás nélkül gyakorlatilag gyógyíthatatlan betegség, halálos kimenetelű. A vírus az állatok testváladékaival, főként nyálával terjed. Valamennyi melegvérű állat fogékony a fertőzésre, közülük is a rókák, kutyák és a farkasok a legfontosabb fertőzésforrások. A veszettség elleni védőoltást éppen ezért mindenkinek meg kell kapnia előzetesen, akinél fennáll a megfertőződés veszélye, vagy utólagosan állatharapás miatt. A veszettség elleni védőoltás hatékonyan védi az embereket és háziállataikat a betegségtől. A védőoltások azoknak ajánlottak, akik olyan magas kockázatú területeken élnek vagy dolgoznak, ahol a veszettség gyakori.

A veszettség elleni specifikus kezelés nincs és nem is várható. Mivel a veszettség vírusának emberbe jutása harapásos seben keresztül történik, a sebellátást mihamarabb el kell végezni, megfelelő oldattal ki kell mosni, majd sebészi ellátás szükséges. Egyidejűleg tetanusz elleni védelmet adni, illetve dönteni kell a veszettség elleni védekezés indokoltságáról és az ezzel kapcsolatos teendőket el kell végezni. Magyarországon a veszettségfertőzésre gyanús esetekben a korábban veszettség elleni védőoltásban nem vagy 5 évnél régebben részesült személyt három alkalommal kell védőoltásban részesíteni 4 adag oltóanyaggal (2-1-1 adaggal) a 0., 7. és 21. napon. A fokozott fertőződési veszélynek kitett, valamint a csökkent védekezőképességű személyeknek (szerzett vagy veleszületett immunhiány) öt alkalommal összesen hat adag oltóanyagot kell beadni: a 0. napon 2x1 dózis, a 3., 7., 14. és 28. napokon egy-egy dózis.
Tetanusz (Merevgörcs)
A tetanusz betegséget vagy merevgörcsöt egy baktérium, a Clostridium tetani okozza, pontosabban egy anyag, un. toxin, amit a baktérium termel miután a szervezetünkbe jutott. A kórokozó rozsdás, földdel szennyezett tárgyakkal történő sebzés vagy állatharapás útján juthat be a szervezetbe. A betegség a vázizomzat bénulását és görcsét okozza. A tünetek a fertőzést követően 8 nap és több hónap közötti intervallumban jelentkezhetnek, és a tünetek jelentkezésekor a betegség már gyógyíthatatlan, halálos kimenetelű. A kötelező védőoltásoknak köszönhetően Magyarországon minden gyermek, aki 16 évnél fiatalabb védett a betegséggel szemben. Kutyaharapás esetén, súlyos kutyaharapás esetén a tetanusz nevű betegségre is gondolni kell, de - mivel a tetanusz ellen kötelező az oltás - gyermekkorban ez elég ritka. Minden harapott seb esetén szükség van a sérült tetanusz elleni védettségének felülvizsgálatára. Aki nem kapott tetanusz emlékeztető oltást a sérülést megelőző 5 évben, annak mindenképpen szükséges az ismétlőoltást beadni.
Bakteriális Fertőzések
A kutyák szájában, nyálában lévő sok-sok baktérium bekerül a sebünkbe, ahol ideális körülményeket találnak a szaporodásra. Emiatt a harapott sebeket, bármilyen furcsa is, nyitva szükséges kezelni. Magyarul ritkán varrjuk meg ezeket. Egyrészt sok baktérium érzékeny az oxigénre, másrészt óhatatlan, hogy a seb váladékozzon, ha nyitva van, az könnyen kontrollálható. A P. multocida és a C. canimorsus baktériumok megtalálhatóak az egészséges kutya szájflórájában, és harapáskor átkerülhetnek az ember szervezetébe, ahol elsősorban az gyenge immunrendszerű egyéneknél idézhetnek elő súlyos, akár halálos fertőzést. A kezeletlenül hagyott harapott sebek könnyen elfertőződhetnek, és életveszélyes további szövődményeket is okozhatnak!
Kutyaharapás Ellátása és Kezelése
A kutyaharapás otthoni kezelése csak kisebb, felületes sérülések esetén lehetséges. Tiszta kéz és eszközök - Először is, mosd meg alaposan a kezed szappannal és meleg vízzel, mielőtt a sebet kezelnéd! Fertőtlenítés - Alaposan tisztítsd meg a sebet fertőtlenítő oldattal, például hidrogén-peroxiddal! Kötözés - A sebet fedd steril gézlappal és rögzítsd kötszerrel! Figyeld a seb gyógyulását!
Az orvosi kezelés során a seb sebészi feltárása és fertőtlenítése történik. A szakember antibiotikumos készítménnyel kezeli a sérülést, végül kötözi, rögzíti. A kutyaharapás következményei olykor igen súlyosak. Hosszú gyógyulási folyamattal járhat, és sajnos maradandó hegek is keletkezhetnek.
Arcon lévő harapott sebeket, a rendkívül fontos esztétikai eredmény miatt, nagyon sokszor megkíséreljük zárva (varrva, ragasztva) kezelni, drain (műanyag csövecske, gumicsík) felett, ami segíti a váladék, genny elvezetését.
A harapott sebek kezelésének első és legfontosabb lépése a seb szakszerű és alapos tisztítása. A tisztítás megfelelő kivitelezésével az elfertőződés kockázata csökkenthető. Amennyiben a seb mégis elfertőződik, szükség lehet antibiotikumos kezelésre. Az antibiotikum típusa és a kezelés hossza függ a harapás típusától, súlyosságától és a meglévő egyéb társbetegségektől (autoimmun betegségek, cukorbetegség, kemoterápiás kezelés stb.). Nagyon súlyos esetekben akár közvetlenül a véráramba adott (intravénás) antibiotikum adására is szükség lehet.
Nagy kiterjedt, mély harapások esetén a seb összevarrása is szükséges lehet. Alapvetően azonban nem varrják össze a harapott sebeket, hogy az esetlegesen bejutó kórokozók távozni tudjanak. Ezt segíti a jódtartalmú fertőtlenítőszerek mellett használatos hidrogén-peroxid oldat. A felpezsgő oxigénbuborékok nemcsak mechanikusan tisztítják a sebet, de erős oxidációs képességük miatt hatékonyak a kórokozókkal szemben is.

Teendőkharapott seb esetén
Harapott sebnél a seb otthoni ellátását követően minden esetben érdemes szakszerű segítséget kérni, mivel a seb tisztítása sokszor nem egyszerű feladat, a fertőzésveszély pedig harapott (különösen mély) seb esetén fokozott. Harapott seb esetében az otthoni teendők az alábbiak: a seb tisztítása (néhány percig, kézmeleg folyó vízzel); a sebet szennyező anyagok (fog, szőr, föld, egyéb szennyezők) eltávolítása; a seb körüli szövet óvatos nyomásával enyhe vérzést megindítani, hogy tisztuljon a seb (kivéve, ha a seb már önmagától is erősen vérzik); az erősen vérző sebre steril kötszert nyomva a vérzés csillapítása; a seb körüli szövet szárazra törlése és a seb bekötése steril kötszerrel; ha rendelkezésre áll, jódtartalmú sebfertőtlenítő szer használata (egyéb kenőcs és fertőtlenítőoldat használata orvosi ajánlás nélkül nem javasolt); szükség esetén fájdalomcsillapító és gyulladáscsökkentő gyógyszer adható a sérültnek (NSAID-ok).
Ha a harapás következtében nagyobb szövetdarab (ujj, fül stb.) szakadt le, azt folyó vízzel öblítse le, tekerje steril kötszerbe, és egy jéggel teli külön zacskóban tárolja. Ilyenkor azonnal hívni kell a 112-t, és kérni a mentők segítségét! Erre szükség lehet akkor is, ha a sérülés súlyos. Például több helyen is harapott a kutya, vagy a seb nagyon mély, erősen vérzik, illetve ha az áldozat eszméletét vesztette.
Kutyaharapás Megelőzése
A kutyusok akkor harapnak, ha valamilyen módon fenyegetve érzik magukat. A sérülés és a betegség szintén gyakori ok. Kutyusod motiválása és jutalmazása a napi kapcsolatotok fontos része - ehhez jól jön néhány egészséges falat! Az izlandi tőkehal tallérok, izlandi farkashal- és tőkehal bőr rágókák tökéletes választás. Mindennapos használatukkal csökkenhet a barna foglepedék, fogkő, és javulhat a kutya lehelete is.
Már korán szocializáld. Fontos, hogy nyugodt és pozitív körülmények között találkozhasson különböző típusú emberekkel, beleértve a gyerekeket, fogyatékkal élőket és időseket, valamint más ebekkel is játszhasson. Ha egy kutya agresszívvé válik, ne fuss el, és ne kiabálj. Tanulj meg olvasni a kutya testbeszédéből, hogy felismerd, mikor stresszes vagy ideges.
Kutyádat mindig tartsd pórázon vagy bekerített területen. Ne próbálj megközelíteni vagy megérinteni egy ismeretlen kutyát anélkül, hogy előbb engedélyt kérnél a gazdától. Amennyiben ismeretlen kutyával találkozol, hagyd, hogy a kutya közelítsen, meg tudjon szaglászni. Ne nyúlj hozzá, hogy megsimogasd, hacsak a gazdája nem adott rá engedélyt. Soha ne alkalmazz a kutya nevelése során bármilyen agressziót, ne szidalmazd.
Fontos, hogy soha ne bagatellizáld el a kutyaharapást, még ha kisebb sérülésekről is van szó. A felszínen semmiségnek látszó kutyaharapás is súlyossá válhat. Fontos megbizonyosodni az állat veszettség elleni oltásának meglétéről és annak érvényességéről, amelyet az állat egészségügyi kiskönyvében (vagy állatútlevelében) tekinthet meg. Ha az oltottság nem bizonyítható, a kezelés során úgy kell eljárni, mintha az állat veszett lett volna.

A legfontosabb megelőző intézkedés a védőoltás. A veszettség elleni védőoltás hatékonyan védi az embereket és háziállataikat a betegségtől. Oltassa be háziállatait: A macskák, kutyák és görények beolthatók veszettség ellen. Tartsa háziállatait bezárva: Tartsa háziállatait bent, és felügyelje őket, amikor kint vannak az udvaron. Védje a kis háziállatokat a ragadozóktól: A nyulakat és más kis háziállatokat, például tengerimalacokat tartsa bent vagy védett ketrecben, hogy biztonságban legyenek a vadállatoktól. Ne közelítsen a vadon élő állatokhoz: A veszettséggel fertőzött vadállatok látszólag nem félnek az emberektől. Fontolja meg a veszettség elleni védőoltás beadatását, ha olyan helyre utazik, vagy gyakran tartózkodik veszettséggel fertőzött állatok közelében.
A kutyaharapás esetén az egyik legfontosabb dolog, hogy ne essünk pánikba! Lássuk el a sebet és ha ezzel kész vagyunk, lehetőleg rövid időn belül derítsük ki, ki a kutya gazdája! Miért? Mert csak tőle tudhatjuk meg, hogy a háziállat be van-e oltva veszettség ellen. A sebet a legtöbb esetben érdemes megmutatni az orvosnak, aki amellett, hogy ellátja a sérülést, később a folyamatos kötéscserét is elvégzi majd.
Jogi Következmények
Azt, hogy ki a felelős a kutya károkozásáért, a Polgári Törvénykönyv szabályozza. A jogszabály úgy fogalmaz, hogy aki állatot tart, az kedvence által másnak okozott kárért is felel. Kutyaharapás esetén a legtöbbször a kutya tulajdonosával szemben lehet bejelenteni a kárigényt, de ez incidensenként változhat. Ha például a kutyus kiszökik a kerítésen, akkor egész biztosan a gazdi az, aki felelősségre vonható.
Floridai kutyaharapás-törvények: Ki a felelős a kutyaharapásért?
Az Országos Rendőr-főkapitányságot is megkerestük azzal a kérdéssel, hogy a kutyatámadásnak milyen jogi következményei vannak a gazdára nézve. Az ORFK tájékoztatása szerint számos tényező enyhítheti, vagy éppen súlyosbíthatja az adott szituációban a felek felelősségét, a rendőrség pedig mindig az ügy összes körülményének ismeretében járhat el. Az elmúlt évek bíróságig jutó ügyei során leginkább a súlyos, vagy életveszélyes sérülést okozó kutyatámadások esetén ítéltek letöltendő szabadságvesztést.
tags: #kutyaharapast #szorevel #nemetul